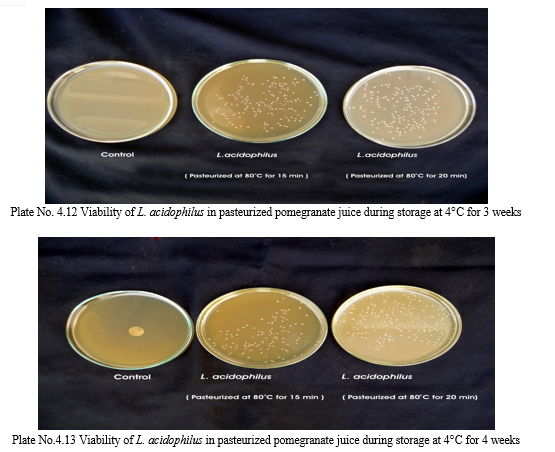

Ijraset Journal For Research in Applied Science and Engineering Technology
Authors: Rohit Narayan Tiwari, Divya Singh, Dr. (Prof.) Indu K. Tripathi, Dr. Narendra Tripathi
DOI Link: https://doi.org/10.22214/ijraset.2022.46712
Certificate: View Certificate
The study was undertaken for production of probiotic pomegranate juice through its fermentation by two strains of lactic acid bacteria: Lactobacillus plantarum & L. acidophilus. Pasteurization of freshly prepared pomegranate juice at 80°Cfor 15 min was conducted to decrease the microbial population to below the detection limit. Fermentation was carried out at 37°C for 72 hrs. The parameters like, microbial population, pH, titrable acidity, and sugar (glucose) were measured during the fermentation period and viability of all the strains was also determined during the storage time at 4°C within week. The results indicated that L. plantarum & L. acidophilus decreased the pH sharply at initial stages of fermentation, sugar consumption was also higher and better microbial growth was also observed for these two strains during fermentation. L. acidophilus showed higher viability during the storage time than L. plantarum. Viable cells remained at their maximum level within 2 weeks but decreased dramatically after 3 weeks. The Pomegranate juice proved to be a suitable media for production of a probiotic drink.
I. INTRODUCTION
Probiotic has been defined as alive or dead organism from Lactobacillus, Streptococcus, Enterococcus, Bacillus and Saccharomyces genera as well as microbial fermentation products, nucleotides and its metabolizable products, metabolites and organic acids (Ouwehand et al., 1999). Probiotics are live microorganisms that are similar to beneficial microorganism found in the human gut. They are also called “Friendly bacteria or good bacteria”. Certain intestinal microbes are known to produce vitamins and they are non-pathogenic, their metabolism is non-putrefactive, and their presence is correlated with a healthy intestinal flora. The metabolic end products of their growth are organic acids (lactic and acetic acids) that tend to lower the pH of the intestinal contents, creating conditions less desirable for harmful bacteria. Probiotics also influence other protective functions of the intestinal mucosa including synthesis and secretion of antimicrobial peptides. The Gastro Intestinal tract also serves as large mucosal surfaces that bridge the gap between ‘inside the body’ and ‘outside the body’. Along this mucosal interface, microbes and foreign antigens colonizing or passing through the Gastro Intestinal tract interact with important components of the immune system. Normal microbial inhabitants of the Gastro Intestinal tract also reinforce the barrier function of the intestinal lining, decreasing ‘translocation’ bacteria from intestine into the blood stream. This function has been suggested to decrease infections. (Pascual et al., 1996)
Fruits and vegetables as functional foods are enriched with minerals, vitamins, dietary fibres, and antioxidants (Phytochemicals). It has been suggested that fruit juices could serve as suitable media for cultivating probiotic bacteria (Mattila et al., 2002).
Pomegranate (Punica granatum, punicaceae) is known to have health-promoting properties with antimicrobial, antiviral, anticancer, antioxidant and antimutagenic effects (Negi et al., 2003). The fresh juice contains 85.4% water and considerable amounts of total soluble solids (TSS), total sugars, reducing sugars, anthocyanins, phenolics, ascorbic acid, proteins and has been reported to be a rich source of antioxidants. These antioxidants are more potent, on a molar basis, than many other antioxidants including vitamin C, vitamin E, coenzyme Q-10 and alpha-lipoic acid (Aviram et al.,2002).
The Microorganisms from several selected bacterial genera such as Bacillus coagulants, Bifidobacterium, Enterococcus faecium, Lactobacillus casei, Lactobacillus acidophilus, Streptococcus , Lactococcus, Lactobacillus plantarum, Lactobacillus paracasei, Lactobacillus delbrueckii are currently utilized as probiotics (Yoon et al., 2004).
Lactic acid bacteria (LAB) have long history of application in fermented foods because of their beneficial influence on nutritional, organoleptic and shelf-life characteristics. Lactobacillus acidophilus is a member of one of the eight main genera of Lactic acid bacteria.
L. acidophilus is characterized as being a rod shaped motile bacteria grows in the presence of oxygen. L. acidophilus is also characterized as a homo fermentative that only produces lactic acid as its sole products. L. acidophilus is important in the fermentation of many foods from dairy products to fruits and vegetables. Fermentation occurs when bacteria break down sugars and carbohydrates to produce alcohol, carbon dioxide and lactic acid Lactobacilus are able to live in highly acidic environments of pH 4-5 , L. acidophilus can help maintain a healthy balance of intestinal flora by increasing acidity of the intestine, killing off harmful bacteria. L. acidophilus was demonstrated to have antimicrobial effects against pathogen.
L. plantarum is rod shaped. Its genome is the largest among all lactic acid bacteria. L. plantarum is also commonly used for food fermentation and turn sugars into lactic acid or alcohol (heterofermentative). It is a facultative anaerobic bacterium. It can convert oxygen into hydrogen peroxide, which gives itself a high hydrogen peroxide tolerance. L. plantarum can survive low pH of the stomach and it can enhance the intestinal integrity, metabolic activity of intestinal cells and stimulate immune responses.
As the market for functional food grows and probiotic microorganism conferring health benefit on the host so these products are gaining a great attention by the consumers. It is playing significant role improvising consumer health.
II. MATERIALS AND METHODS

A. Bacterial Strain And Culture Used
B. Collection and Maintenance of Microbial Strains and Culture
Lactic acid bacterial isolates namely Lactobacillus acidophilus and Lactobacillus plantarum were collected from MCCB (Microbiological Culture Collection Bank) and these cultures were revived in MRS broth and they were then sub cultured on MRS agar slants and incubated at 30°C for 24-48 hrs. The cultures were maintained at 4°C and for each trial 24 hrs. Old broth cultures were used.
C. Preparation of Pomegranate Juice
The purchased fresh pomegranate was washed with tap water to remove soil and other impurities, dried at room temperature prior to use. Pomegranate fruits were peeled and the skin covering, removed manually. The pomegranate fruits were ground and filtered to separate pomegranate juice.
D. Heat Treatment And Fermentation Of Pomegranate Juice
The pomegranate juice was pasteurized for 20 min at 80°C. 24 hours cultivation if lactic acid bacteria in the MRS broth were carried out at 30°C. For obtaining initial cell density of 107 cfu/ml in the final juice, 15 ml of cultivated MRS broth was centrifuged at 4,000g for 10 min and the biomass was introduced into the juice (150 ml). The juice was then incubated at 30°C for 72 hours and samples were taken every 24 hours for determination of pH, acidity, sugar and total bacterial count.
E. Determination Of Ph, Lactic Acid Content, Reducing Sugar (Glucose), And Total Bacterial Count In Probiotic Pomegranate Juice
Sample was taken at every 24 hours intervals for determine the probiotic properties pomegranate juice.
F. pH Measurement
pH was measured with a pH meter at every 24 hours, the calibration of pH meter was assured so that correct result could be measured.
G. Total Acidity
Total acidity was determined by the fruit juice sample (5ml) was homogenized in distilled water (20ml) and filtered through what man No.1 filtered paper. Two-three drops of phenolphthalein were added 20 ml of the filtrate as indicator and titrated against 0.05M NaOH to the end point of phenolphthalein. Titrable acidity was expressed as g lactic acid /100g of juice and calculated using the following formula.
Titrable acidity (g/100g) =volume of NaOH(ml) used in titration X MNaOH x 0.09×100
ml juice sample
Where, TA = titrable acidity; MNaOH = Molarity of NaOH used; ml NaOH = amount (in ml) of NaOH used; 0.09 = equivalent weight of lactic acid
H. Sugar Content
Sugar content was analyzed as glucose by phenol sulphuric acid method ,phenol sulphuric acid method was conducted into boiling tube. Sample was hydrolysed with 2.5N HCl and neutralized it with the solid sodium carbonate until the effectiveness ceases. Standards were prepared by taking 0, 0.2, 0.4, 0.6, 0.8 and 1ml of the working standard. ‘0’ serves as blanks and volume was made to 1 ml in all the tubes including the sample tubes by adding distilled water. Sample was centrifuged and collected supernatant and took aliquots for analysis. Sample was pipette out and then added phenol solution, 96% sulphuric acid to each tube. Sample was placed in a water bath at 25-30°C for 20 min, read the colour at 490 nm. Standard graph was drawn by concentration of the standard on the x axis versus absorbance on the y axis.
I. Viable cell counts (cfu/ml)
Viable cell counts (cfu/ml) were determined by the standard plate method with Lactobacilli MRS (Man-Rogosa Sharp Agar) medium. Serial dilutions were made in ringer’s solution and diluted juice sample was mixed with the medium (MRS). The dishes were incubated at 30°C for 24 to 48 hours and the bacterial colonies were recorded.
J. Effect Of Cold Storage On Cell Viability In Probiotic Pomegranate Juice
After 72 hours of fermentation at 30°C, the fermented samples (25 ml) were stored at 4°C for 4 weeks. Samples were taken at weekly intervals, and viability of probiotic cultures in probiotic pomegranate juice was determined. Viable cell counts (cfu/ml) were determined by the standard plate method with Lactobacilli MRS (Man-Rogosa Sharp Agar) medium. Serial dilutions were made in ringer’s solution and diluted juice sample was mixed with the medium (MRS). The dishes were incubated at 30°C for 24 to 48 hours and the bacterial colonies were recorded.
K. Statistical Analysis
The data recorded during the course of investigation were subjected to two way anova and conclusions were drawn accordingly. (Fisher and Yates, 1990)
Table 1: Skeleton of ANOVA table
|
Source of variation |
df |
SS |
MSS |
F Cal |
F Tab at 5% |
|
Due to replications |
(r-1) |
RSS |
RSS (r-1) |
MSS(r) EMS |
|
|
Due to treatments |
(t-1) |
TrSS |
TrSS (t-1) |
MSS(t) EMS |
|
|
Due to error |
(r-1)(t-1) |
ESS |
ESS (r-1)(t-1) |
|
|
|
Total |
(rt-1) |
TSS |
|
|
|
Where,
Standard Error Deviation (SEd)
Standard error of mean was calculated by the following formula:

Critical differences (CD)
Critical difference was calculated by the following formula:
CD = SEd x‘t’ error degree of freedom at 5%
r = Number of replication
df = Degree of freedom
SS = Sum of squares
RSS = Sum of squares due to replication
TrSS = Sum of squares due to treatment
TSS = Total sum of squares
ESS = Error sum of squares
MSS(r) = Mean sum of squares due to replication
MSS (t) = Mean Sum of squares due to treatment
EMS = Error mean sum of squares
SEd = Standard error deviation
III. RESULT AND DISCUSSION
A. Production of Probiotic Pomegranate juice by L. acidophilus under Pasteurized Condition
Lactic acid bacteria, (L.acidophilus, L.plantarum) used in this study was capable of growing well on sterilized juices without any nutrient supplementation. Pasteurization was carried out at 80°C for 15 min and 20 min, no significant changes were detected in sugar, acidity, and pH. Heat treatment (Pasteurization) is generally used to eliminate or reduce the contaminant microorganisms. The main requirement of heat treatment is to ensure the microbial safety of the product. The time course of lactic acid fermentation of pomegranate juices by Lactobacillus spp. is presented in Table 4.1 and 4.2.
Table 2: Effect of fermentation time on pomegranate Juice by L. acidophilus (Pasteurization at 80° C for 15 min):
|
Time (h) |
pH |
Acidity (g/100g) |
Sugar (mg/ml) |
CFU/ml×107 |
|
0 |
3.09 |
2.88 |
0.494 |
9.9 |
|
24 |
3 |
3.16 |
0.394 |
17 .5 |
|
48 |
2.90 |
3.52 |
0.208 |
14. 5 |
|
72 |
2.50 |
3.60 |
0.19 |
12.5 |

B. Variation in pH of Pomegranate Juice During Fermentation
Although the Pomegranate juice had an initial pH value of 3.09 in 15 min pasteurized juice and 3.41 in 20 min pasteurized juice sample. Table 4.1 and 4.2 show the lactic acid cultures actively fermented the pomegranate juice and lowered the pH as low as 2.50 and 3.0 after 72 hours fermentation. According to Figure 4.1, the pomegranate juice pasteurized for 15 min shows faster reduction in pH after 48 hours, compared with juice pasteurized for 20 min. Babu et al. (1992) reported that addition of tomato juice to skimmed milk stimulated the growth of L. acidophilus and resulted in higher viable counts, shorter generation time, and improved sugar utilization with more acid production and lower pH.

C. Variation in Acidity Expressed as lactic acid of Pomegranate juice During Fermentation by L. Acidophilus
During fermentation of pomegranate juice, production of lactic acid was determined. Result indicated that the lactic acid produced by all the strains and its concentration increased as the fermentation commenced. Figure 4.2 shows the changes in acidity during pomegranate juice fermented by L. acidophilus. Although the Pomegranate juice had an initial acidity 2.88 in 15 min pasteurized juice and 2.16 in 20 min pasteurized juice and its concentration was increased after 48 hours fermentation. L.acidophilus produced significantly more titrable acidity in 15 min of pasteurized juice than 20 min of pasteurized juice. According to Holzapfel and Schillinger (2000), acid tolerance is an important probiotic trait for surviving during fermentation in food medium. De vries and Stouthamer (1967) reported that strains metabolized citric acid as the major carbon source available in pomegranate juice. Since lactic acid is recognized as the main metabolite produced by lactic acid bacteria.

D. Variation in glucose concentration of pomegranate juice during fermentation L. acidophilus
Determination of glucose concentration in pomegranate juice was done during fermentation. Changes in sugar content during pomegranate juice fermented by L. acidophilus are given in Figure 4. 3. L. acidophilus rapidly fermented pomegranate juice and reduced the level of sugar. The Glucose concentration was decreased from 0.494 mg/ml to 0.19mg/ml in 15 min pasteurized juice and 0.566 mg/ml to 0.246 mg/ml in 20 min pasteurized juice after 48 hrs fermentation. L. acidophilus utilized significantly more glucose in juice for 20 min of pasteurization than 15 min. In the research of Tezcan et al. (2009) glucose and fructose were dominant sugars in pomegranate juice. The concentration of glucose reduced significantly in comparison to fructose between hours 48 an 72 of the fermentation.

E. Variation in microbial population of pomegranate juice during fermentation L. acidophilus
Changes in viable cell count during pomegranate juice fermented by L. acidophilus w grew rapidly in pasteurized pomegranate juice and reached a viable cell population 12.5 x107 in 15 min pasteurized juice and 9.5 x107in 20 min pasteurized juice after 48 hours fermentation at 30°C. Shamala et al. reported that the optimum temperature for growth of L. acidophilus was 30°C. Extending the fermentation beyond 48 hours resulted in a significant decrease in the viable cell counts of lactic acid bacteria at 30°C. Yanez et al. (2008) also reported that low pH of the medium can lead to the decrease in maximum growth rate and extended length of the lag phase. This stage was clearly detectable for all the strains during which metabolic activity including sugar consumption and acid production is minor and the bacterial cell try to adapt with the new conditions.



G. Variation in pH of pomegranate juice during fermentation by L. plantarum
Although the Pomegranate juice had an initial pH value of 3.09 in 15 min pasteurized juice sample and 20 min pasteurized juice sample. The lactic acid cultures actively fermented the pomegranate juice and lowered the pH as low as 3 after 72 hours fermentation.

H. Variation in acidity expressed as lactic acid of pomegranate juice during fermentation by L. plantarum
Pomegranate juice had same initial acidity 1.29 in 15 min pasteurized juice and its concentration was increased after 48 hours fermentation. Figure 4.6 shows the changes in acidity during pomegranate juice fermented by L. plantarum. L. plantarum produced significantly more titrable acidity in 15 min pasteurized juice than 20 min pasteurized juice. Sindhu and khetrapaul (2001) was reported that probiotic fermentations of indigenous food mixture containing tomato pulp using L.plantarum showed a decreased of pH, increased of acidity, and improvement of digestibilities of starch and protein.

I. Variation in Glucose Consumption of Pomegranate Juice During Fermentation
Determination of glucose concentration in pomegranate juice was done during fermentation. Changes in sugar content during pomegranate juice fermented by L. plantarum are given in Figure 4.7. L. plantarum rapidly fermented pomegranate juice and reduced the level of sugar. Glucose concentration was decreased from 0.122 mg/ml to 0.082 mg/ml in 15 min pasteurized juice sample and 0.254mg/ml to 0.038 mg/ml in 20 min pasteurized juice after 48 hrs fermentation. L. plantarum utilized significantly more glucose in juice for 20 min of pasteurization than 15 min. Hou et al. (2000) proved that metabolism of carbohydrates by Lactobacillus varies from strain to strain and depends on the substrate and even on the fermentation time and Wang et al. (2003) also reported that glucose is a very good carbon and energy source for Lactobacilli.

I. Variation in Microbial population of pomegranate juice during fermentation by L. plantarum
Changes in viable cell counts during pomegranate juice fermented by L. plantarum are given in Figure 9. Lactic acid culture grew rapidly in pasteurized pomegranate juice and reached a viable cell population 4.2 x107 in 15 min pasteurized juice and 3.9 x107in 20 min pasteurized juice sample after 48 hours fermentation at 30°C. The management of the fermentative process is important from several points of view, among which obtaining drinks with desirable sensory characteristics and existence of at least 107 CFU lactic acid bacteria /ml, which make the drink a probiotic product. Some authors were reported that acid production ability by lactic acid bacteria, especially post acidification, affected the cell viability of probiotic bacteria.


K. Effect of cold storage(4°C) on the viabilityof lactic acid cultures in fermented probiotic pomegranate juice
Fermentation of pomegranate juice using Lactic acid cultures at 30°C for 72 hours provided the products containing higher than106 cfu/ml after storage for 3 week at 4°C. Conversely, It was reported that the probiotication provided the high number of the cells above the benefit level in fruit juices, the sensory characteristics of the product were not accepted by the consumers. The above pic. illustrates the effect of cold storage on the viability of Lactobacillus acidophilus in fermented juices.
Table 6: Effect of cold storage (4°C) on the viability of L. acidophilus in probiotic pomegranate juices
|
Time in Weeks |
L. acidophilus |
|
|
|
Probiotic pomegranate juice (Pasteurized at 80°C for 15 min) |
Probiotic pomegranate juice (Pasteurized at 80°C for 20 min) |
|
|
Stored at 4°C |
Stored at 4°C |
|
|
CFU/ml x107 |
CFU/ml x107 |
|
0 |
12.5 |
9.5 |
|
1 |
12.0 |
9.6 |
|
2 |
7.5 |
7.4 |
|
3 |
7.4 |
7.2 |
|
4 |
6.9 |
6.5 |

L. Survival of lactic acid bacteria in fermented pomegranate juice during cold storage
The Lactobacillus spp. was capable of surviving at low pH and high acidity condition in the fermented pomegranate juice. Figure 4.9 shows that the microbial population of L. acidophilus in 15 min pasteurized juice was decreased to 6.9 x107cfu/ml and 6.5 x107 cfu/ml in 20 min pasteurized juice even after 3 weeks at 4°C. L. acidophilus shows better viability in 15 min pasteurized juice than that grown in 20 min pasteurized juice. The reason could be addressed to the lack of their ability to survive in the stressful condition of low pH and high acidity of the pomegranate juice and also relatively low temperature of the environment (4°C). Similar results were obtained for fermented tomato juice by other authors (Yoon 2004).

M. Effect of cold storage(4°C) on the viabilityof lactic acid cultures in fermented probiotic pomegranate juice
The viable cell counts of L. plantarum decreased slightly during cold storage, but the cell viability of the L. plantarum remained at a considerably high level (107cfu/ml) after 3 weeks of cold storage. Table 4.13 illustrates the effect of cold storage on the viability of Lactobacillus plantarum in fermented juices.
Table 7 Effect of cold storage (4°C) on the viability of L. plantarum in probiotic pomegranate juices
|
Time in Weeks |
L. plantarum |
|
|
|
Probiotic pomegranate juice (Pasteurized at 80°C for 15 min) |
Probiotic pomegranate juice (Pasteurized at 80°C for 20 min) |
|
|
Stored at 4°C |
Stored at 4°C |
|
|
CFU/ml x 107 |
CFU/ml x107 |
|
0 |
4.2 |
3.9 |
|
1 |
5.5 |
4.5 |
|
2 |
4.5 |
4.0 |
|
3 |
4.2 |
3.5 |
|
4 |
3.3 |
2.5 |

N. The survival of lactic acid bacteria in fermented pomegranate juice during cold storage:
In Figure 12 L. plantarum shows better viability in15 min pasteurized juice than that grown in 20 min pasteurized juice. According to Shah (2001) it is important to have a significant number of viable lactic acid bacteria present in the probiotic products for maximum health benefits. According to Dave and Shah (1997) Lactic acid starters are reported to produce bacteriocin against probiotics bacteria and vice versa. In general, the cell viability depends on the strains used, interaction between species present, culture condition, oxygen content, and final acidity of the product and the concentration of lactic acid. The main factor for loss of viability of probiotic microorganism have been attributed to the decrease in pH of the medium and the accumulation of organic acid as a result of growth and fermentation (Hood and Zottola, 1998)



It is concluded that the fermented pomegranate juice could be used as raw material for lactic acid fermentation and the product could serve as a healthy beverages for consumers who are allergic to dairy product. Both L. planatrum and L. acidophilus are suitable for use as probiotics cultures for the production of probiotics fruit juices. During the fermentation process there is an accumulation of acid with higher rate in case of L. acidophilus which make the pomegranate juice much pleasant in terms of sensory trades. Fermented pomegranate juice could be recommended to be used for the preparation of food based product process by lactic acid fermentation.
[1] Dubios, M., Gilles, K.A., Hamilton, J.K., Roberts, D.A. and Smith, F. (1956). Colormetric methods for determination of sugars and related substances. Analytical Chemistry. 28: 350-356. [2] De Vries, W. and Stouthamer, A.H. (1967). Pathway of glucose fermentation in relation to the taxonomy of Bifidobacteria. Journal of Bacteriology. 93: 574-576. [3] Fuller, R. (1989). Probiotics in man and animals. Journal of Application of Bacteriology. 66: 365-378. [4] Fisher, R. A. and Yates, F. (1990) Statistical table for biological agriculture and medical research. Alivas and Boyd Edinbury. 4: pp 251-28. [5] Babu, V., Mital, B. K. and Grag, S. K. (1992). Effect of tomato juice addition on the growth and activity of Lactobacillus acidophilus. International Journal of Food Microbiology. 17(1): 67-70. [6] Ishibashi, N. and Shimamura, S. (1993). Biofidobacteria: Research and development in Japan. Food Technology. 47: 126-136. [7] Shah, N. P., Lankaputhra, W. E. V., Britz, M. and Kyle, W. S. A. (1995). Survival of L. acidophilus and Biofidobacterium bifidum in commercial yogurt during refrigerated storage. Journal of International Dairy. 5: 515-521. [8] Pascual, M., Garriga, M. and Morfort, J. M. (1996). Los Probiotics en la aliment action animal. Eurocarne. 44: pp46-53. [9] Dave, R. I. and Shah, N. P. (1997). Viability of yogurt and Probiotics bacteria in yogurt made from commercial starter culture. Journal of International Dairy. 7: 31-41. [10] Hood, S. K. and Zottola, M. L. (1998). Effect of low pH on the ability of Lactobacillus acidophilus to survive and adhere to human intestinal cell. Journal of Food Sciences. 53: 1514-1516. [11] Berner, L. and Odonnell, J. (1998). Functional foods and health claims legislation: Application to dairy foods. Journal of International Dairy. 8: 355-362. [12] Berner, L. and Odonnell, J. (1998). Functional foods and health claims legislation: Application to dairy foods. Journal of International Dairy. 8: 355-362. [13] Narvhus, J. A., Osteraas, K., Mutukumira, T. and Abrahamsen, R. (1998). Production of fermented milk using a malty compound producing strain of Lactococcus lactis isolated from Zimbabwean naturally fermented milk. International Journal of Food Microbiology. 41: 73-80. [14] Ouwehand, A. C., Kirjavainen, P. V., Shortt, C. and Salminen, S. (1999). Probiotics: mechanics and established effects. International Dairy Journal. 9: 43-52. [15] Segal, R. (1999). Alimente de protective. In Alimente Functionale 5(2): 255-294. [16] De Vuyst, L. (2000). Technology aspects related to the application of functional starter cultures. Food Technology Biotechnology. 38(2): 105-112. [17] Holzapfel, w. H. and Schillinger, U. (2000). Introduction to pre and probiotics. Food Research Internationa. 35: 109-116 [18] Gil, M., Tomas, F.A., Hess, B., Holcroft, D. and Kader, A.A. (2000). Antioxidant activity of pomegranate juice and its relationship with phenolics composition and processing. Journal of Agricultural and Food Chemistry. 48: 4581-4589. [19] Hou, J. W., Yu, R. C. and Chou, C. C. (2000). Change in some components of soymilk during fermentation with Biofidobactria. Food Research International. 35: 393-397. [20] Pietschmann, M., Liebl, B. and Burghart, J. (2000). Commercial fermented drinks ingredients, nutritional value and legal classification. Journal of Dairy Science. 96(6): 203-210. [21] Tannock, G.W. (2000). Probiotics and Prebiotics. Trends Food Science Technology. 15: 348-359 [22] Shah, N. P. (2001). Functional foods from probiotics and prebiotic. Food Technology. 5(11): 46-53. [23] Sindhu, S. C. and Khetarpaul (2001). Probiotic fermentation of indigenous food mixture. Journal of Food Compound. 14: 601-609. [24] Chu, Y. F., Sun, J., Wu, X. and Liu, R. H. (2002). Antioxidants and anti-proliferative activities of fruit juices. Journal of Agricultural and Food Chemistry. 43:674-785. [25] Heenan, C. N., Adams, M. C., Hosken, R. W. and Fleet, G. S. (2002). Growth medium for cultivating probiotic bacteria for application in vegetarian food products. Journal of Food Science. 53: 1515-1516. [26] Mattila, T., Myllarinen, P., Crittenden, R., Mogensen, G., Fonden, R. and Saarela, M. (2002). Technological challenges for future probiotic foods. Journal of International Dairy. 12: 173-182. [27] Krasaekoopt, W., Pianjareonlap, R. and Kittisuriyanont, K. (2003). Probiotic Fruit juices. Alivas and Boyd Edinbury. 4: pp 251-289. [28] Negi, P.S., Jayaprakasha, G.K. and Jena, B.S. (2003). Antioxidant and antimutagenic activities of pomegranate peel extracts. Food Chemistry. 80: 393-397. [29] Wang, Y. C., Hou, J.W., Yu, R. C. and Chou, C.C. (2003). Sugar and acid contents in soymilk fermented with lactic acid bacteria alone or simultaneously with Bifidobacteria. Food Microbiology. 20: 333-338. [30] Abdulamir, A.S., Zaman, M.Z., Hafidh, R.R. and Bakar, F.A. (2004). The role of diet, probiotics and prebiotic in the development and management of inflammatory bowel disease. Journal of Microbiology. 24(2): 132-135. [31] Giraffa, G. (2004). Studying the dynamics of microbial populations during food fermentations. Food Technology .47: 126-136. [32] Luckow, T. and Delahunty, C. (2004). A consumer study of probiotic non dairy juice drinks. Journal of Food Science. 59: 350-355. [33] Marica, R., Baras, J. and Vukasinovic, M. (2004). The influence of brewer’s Yeast autolysate and lactic acid bacteria on the production of a functional food additive based on beetroot juice fermentation. Food Technology biotechnology. 42 (2): 109-113. [34] Yoon, K. Y., Woodams, E. E. and Hang, Y. D. (2004). Probiotication of tomato juice by Lactic acid bacteria. Journal of Microbiology. 42 (4): 315-814. [35] Dickerman, J. M. and Liberman, S. (2005). Studied on the chemical nature of lactic acid bacteria present in probiotic cabbage juice. Food Research. 17: 438-444. [36] Yoon, K. Y., Woodams, E. E. and Hang, Y. D. (2005). Production of probiotic cabbage juice by lactic acid bacteria. Department of Food Science and Technology. 42 (4): 315-832. [37] Kohajdova, Z., Karovicova, J. and Greifova, M. (2006). Lactic acid fermentation of some vegetable juices. Journal of Food and Nutrition Research. 45(3): 115-119 [38] Parvez, S., Malik, K.A., Kang, S.A. and Kim H.Y. (2006). Probiotics and their fermented food products are beneficial for health. Journal of Applied Microbiology. 100(6): 1171-1185. [39] Vuyst, D. L. and Leroy, F. (2006). Bacteriocins from lactic acid bacteria production, purification, and application. Journal of Molecular, Microbiology and Biotechnology. 13: 194-199. [40] Fazeli, M.R., Amirmozafari, N., Golbooi, N. R. and Jamalifar, H. (2007). Antagonistic action of watermelon juice probioticated using different strains Lactobacilli against Salmonella typhimurium. Iranian Journal Public Health. 36 (4): pp 70-72. [41] Krasaekoopt, W. and Chea, P. (2007). Probiotication of fruit juices. Journal of Food and Nutrition Research. 23: 56-78. [42] Kraszewska, J., and Wzorek, W. (2007). Changes of the selected properties of Lactobacillus plantarum ATCC 4080 during storage of malt beverage. Food Technology. 6(1): 69-81. [43] Moraru, D., Bleoanca, I. and Segal, R. (2007). Probiotic vegetable juices. Food Technology. 56: 20-21. [44] Sheehan, V. M., Ross, P. and Fitzgerald, G.F. (2007). Assessing the acid tolerance and the technological robustness of probiotic cultures for fortification in fruit juices. Innovative Food Science and Emerging Technology. 8: 279-284. [45] Kun, S., Rezessy-szabo, J. M., Nguyen, Q. D. and Hoschke, A. G. (2008). .Changes of microbial population and some components in carrot juice during fermentation with selected Biofidobacterium strains. Process Biochemistry. 43: 816-821. [46] Prado, F.C., Parada, J.L., Pandey, A. and Soccol, C.R. (2008). Tends in non dairy probiotic beverages. Food Research Internatonal. 41(2): 111-123 [47] Tantipaibulvut, S., Soontornsophan, C. and Luangviphusavanich, S. (2008). Fermentation of roselle juice by lactic acid bacteria. Journal Food Agro and Industry. 1(4): pp 213-222. [48] Yanez, R., Marques, S., Girio, M. F. and Rosiro, J. C. (2008). The effect of acid stress on lactate production and growth kinetics in Lactobacillus Rhamnosus cultures. Process Biochemistry. 43: 356-361. [49] Buruleanu, L., Nicolescu, C. L., Bratu, M. G. and Manea, I. (2009). Survival of Probiotics bacteria during lactic acid fermentation of vegetable juices. Journal of Agro alimentary Process and Technologies. 15(1): pp132-139. [50] Lavinia, B., Nicolescu, C. L., Bratu, M. G. and Manea, L. (2009). Survival of probiotic bacteria during lactic acid fermentation of vegetable juices. Journal of Agro alimentary Process and Technologies. 15(1): pp132-139. [51] Shah, N. P. and Jelen, P. (2009). Survival of lactic acid bacteria and their lactases under acidic conditions. Journal of Food Science. 55: 506-509. [52] Tezcan, F., Ven, G. M., Diken, T., Qzcelik, B. and Erim F. B. (2009). Antioxidant activity and total phenolics, organic acid and sugar content in commercial pomegranate juices. Food Chemistry. 115: 873-877. [53] Jong-Ho, K., Youngshik, K. and Jun-Hyun, O. (2010). Chemical Characterization of tomato juice fermented with biofidobacteria. Journal of Food Science. 75: pp 342-347. [54] Lannitti, T. and Palmieri, B. (2010). Therapeutical use of probiotic formulations in clinical practice. Journal of Clinical Nutrition. 29: 701-725. [55] Mousavi, Z. E., Mousavi S. M., Razavi, S. H., Emam-Djomeh, Z. and Mousavi, H. K. (2011). Fermentation of pomegranate juice by probiotic lactic acid bacteria. World Journal Microbiology and Biotechnology. 27: 123-128. [56] Ruvira, E. Y. and Gallardo, N. Y. (2011). Non dairy probiotic products. Food Microbiology. 27(1): 1-11.
Copyright © 2022 Rohit Narayan Tiwari, Divya Singh, Dr. (Prof.) Indu K. Tripathi, Dr. Narendra Tripathi. This is an open access article distributed under the Creative Commons Attribution License, which permits unrestricted use, distribution, and reproduction in any medium, provided the original work is properly cited.
Paper Id : IJRASET46712
Publish Date : 2022-09-11
ISSN : 2321-9653
Publisher Name : IJRASET
DOI Link : Click Here
Submit Paper Online
